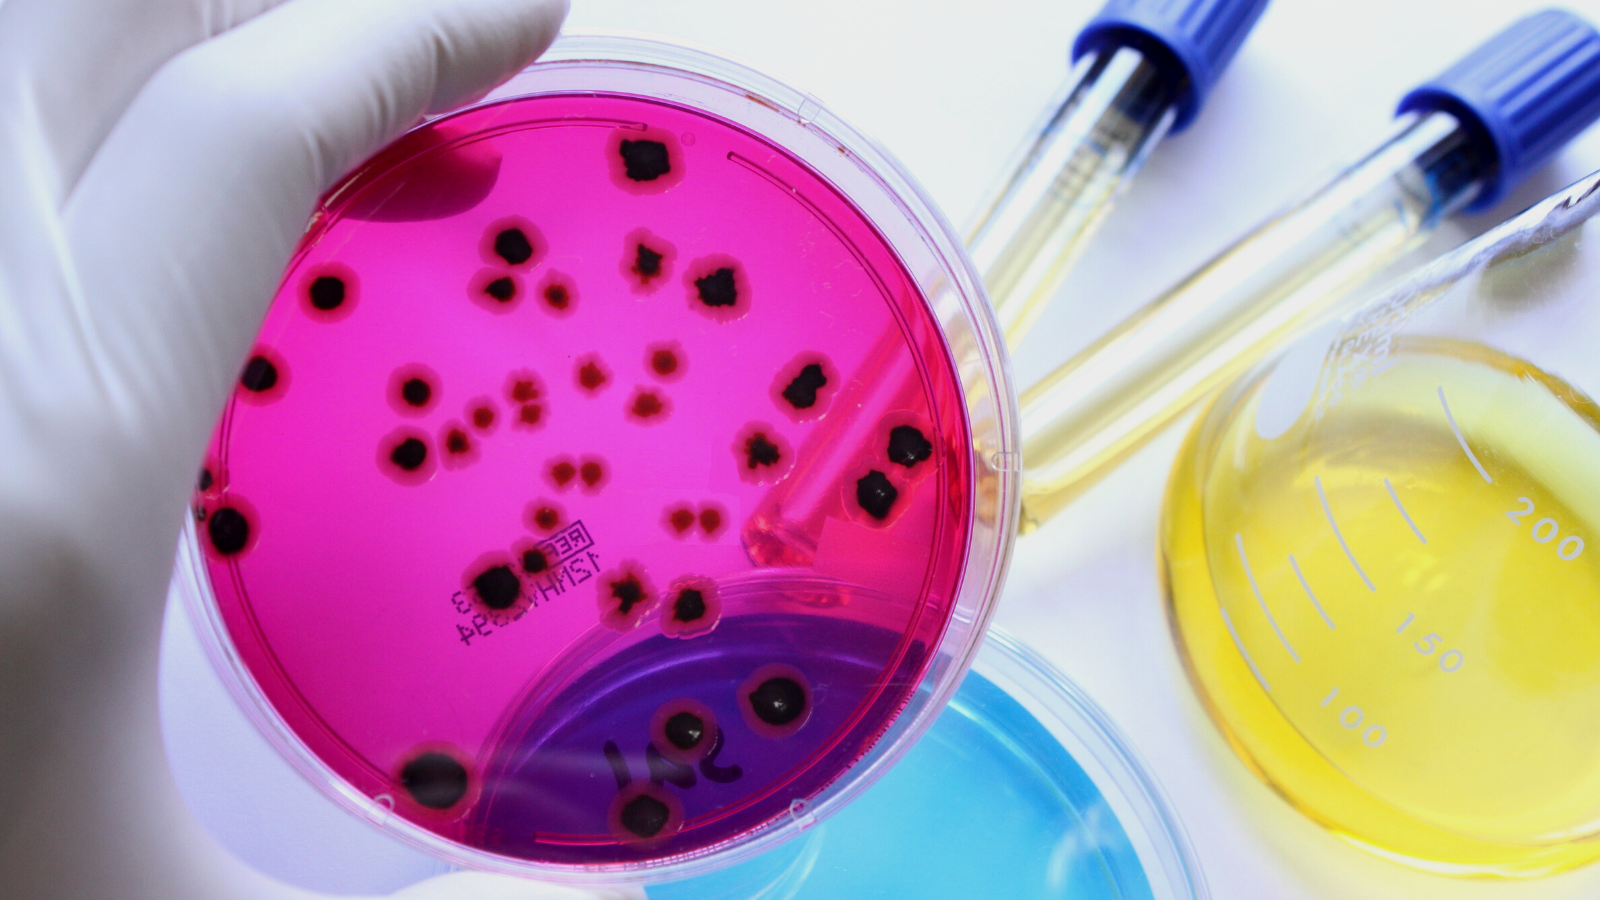
Test cam plakasındaki mikroplar

Küresel uyumluluk, eğitim, test, gözetim, denetim ve belgelendirme hizmetlerimizle tedarik zincirinizdeki riskleri en aza indirerek markanızı koruyun.
Gıda ürünleri için küresel pazarlara erişim karmaşık olabilir. İster tüketici odaklı zevkler ve talepler olsun, ister güvenlik, kalite ve sürdürülebilirliği kapsayan düzenlemeler olsun, her pazarın kendine özgü gereksinimleri vardır.
Gıda işletmelerinin dünyanın dört bir yanındaki pazarlara yüksek kaliteli, güvenli ve uyumlu ürünler sunmasına yardımcı olmak için kapsamlı bir dizi güvence ve danışmanlık hizmeti sunuyoruz. Son teknoloji laboratuvarlar ve yazılım uygulamalarından yararlanan ve aralarında yüksek nitelikli denetçilerin ve gıda güvenliği uzmanlarının da bulunduğu küresel gıda uzmanları ağımız tüm bilgi, risk yönetimi ve uygunluk ihtiyaçlarınızı karşılayan bağımsız çözümler sunar.
Uluslararası kabul görmüş standartlara uygun çok çeşitli test çözümleri sunuyoruz. Yüksek nitelikli analistlerimiz ve endüstri uzmanlarımız, ürünlerinizin müşteri beklentilerini, akreditasyon kuruluşları ve hükümetler tarafından belirlenen gereklilikleri karşılamasını sağlayacaktır. Uzmanlarımız, temel mikrobiyolojik analizlerden gıda sahteciliğine, beslenme veya alerjen testlerine kadar numunelerinizi hızlı, profesyonel ve doğru bir şekilde işler. Ek olarak, gıda etiketi incelemecilerimiz, ürün beyanlarınızın ve etiketlerinizin yasal gerekliliklere uygun olmasını sağlayabilir.
Tedarik zincirinizin yerel ve uluslararası standartlara uygun olmasını sağlamak için dünyanın dört bir yanındaki pazarlarda kapsamlı bir denetim ve belgelendirme hizmetleri yelpazesi sunuyoruz. Buna ek olarak, bir dizi gıda sektöründe üst düzey pazar istihbaratı ve Yapay Zeka kullanarak mevzuat güncellemeleri ve ürün risk tahminleri için bir ufuk tarama hizmeti sunuyoruz.
Profesyonel eğitim sağlamada küresel bir lider olan SGS, gıda güvenliği ve kalite standartlarınızı değerlendirmenize ve iyileştirmenize yardımcı olacak yenilikçi öğrenme ve geliştirme çözümlerine erişmenizi sağlar. Kurslarımız, sürdürülebilirlik dahil olmak üzere gıda değer zincirinizin tüm yönlerini kapsar ve sanal ve e-öğrenme dahil çeşitli formatlarda sunulabilir.
Tüm pazarlarda küresel uzman ağımız ile hizmetlerimiz gıda tedarik zincirlerinizde güven oluşturmanıza yardımcı olur.
Belirli bir şey mi arıyorsunuz?
Gıda içerisinde arayın
Bağlar Mah. Osmanpaşa Cad. No:95,
İş İstanbul Plaza E Girişi, Güneşli, 34209,
İstanbul,
Türkiye